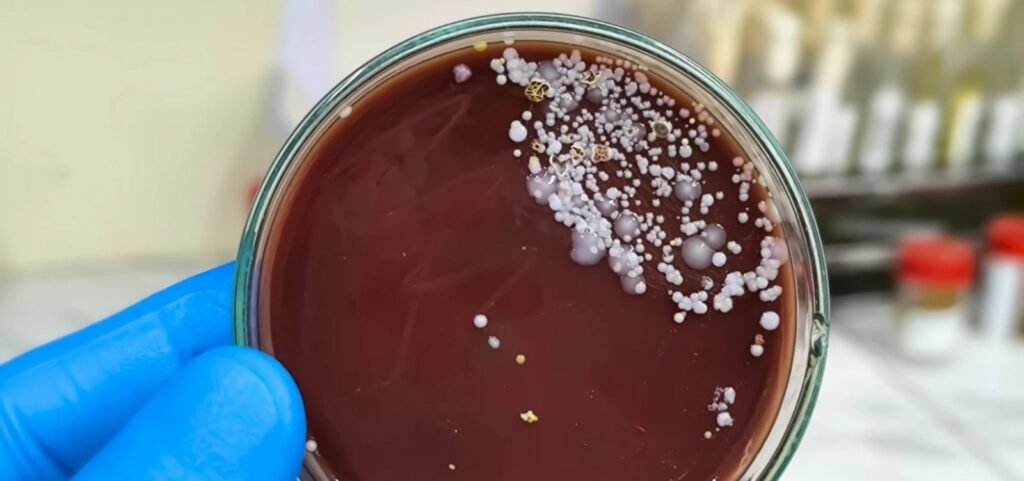

China e EUA se encontrarão para discutir tarifas pela 1º vez

China e Estados Unidos realizarão neste fim de semana, em Genebra, na Suíça, a primeira reunião para tratar das tarifas comerciais impostas por ambos os lados. O encontro ocorre após o aumento das tarifas anunciado pelo presidente Donald Trump em abril, o que gerou retaliação por parte da China e aprofundou a tensão entre as […]
Mega-Sena acumula e prêmio chega a R$ 38 milhões

O concurso 2.859 da Mega-Sena, realizado nesta terça-feira (6) no Espaço da Sorte, em São Paulo, não teve ganhadores na faixa principal. As dezenas sorteadas foram: 07 – 08 – 15 – 17 – 20 – 51. Com isso, o prêmio acumulou e está estimado em R$ 38 milhões para o próximo sorteio, que ocorrerá […]
Câmara aprova aumento no número de deputados para 531 a partir de 2027

O Projeto de Lei Complementar (PLP) aprovado na noite de terça-feira (6) pela Câmara dos Deputados aumenta o número de vagas na Casa de 513 para 531 a partir da legislatura de 2027, em resposta ao crescimento populacional. O texto mantém o tamanho das bancadas que perderiam representantes conforme o Censo de 2022. A proposta […]
Bahia x Nacional: veja onde assistir, horário e prováveis escalações do jogo

O Bahia retoma suas atenções para a disputa da Libertadores. Na noite desta quarta-feira (7), a partir das 19h no horário de Brasília, o Esquadrão de Aço recebe a visita do uruguaio Nacional, na Arena Fonte Nova, pela quarta rodada do Grupo F. O Tricolor é o líder da tabela de classificação com sete pontos, […]
Cardeais celebram última missa antes do conclave nesta quarta

A missa “Pro Eligendo Romano Pontifice” teve início na madrugada desta quarta-feira (7), às 5h (horário de Brasília), na Basílica de São Pedro, no Vaticano. A celebração antecipa o conclave, processo reservado à escolha do novo papa, que sucederá o papa Francisco. Todos os cardeais com direito a voto participam da missa, que marca o […]
Vitória empata com Defensa y Justicia no Barradão e se complica na Sul-Americana

O Vitória se complicou na Copa Sul-Americana. Na noite desta terça-feira (6), o Leão saiu na frente com Edu no primeiro tempo, mas acabou cedendo o empate em 1 a 1 com o Defensa y Justicia, no Barradão, pela quarta rodada. O gol do time argentino foi marcado por Togni, na etapa complementar. Com a […]
Anvisa emite alerta após surtos do “superfungo” em São Paulo e Pernambuco
A Agência Nacional de Vigilância Sanitária (Anvisa) emitiu um alerta de risco após dois surtos do fungo Candida auris registrados este ano. Os registros foram feitos no hospital de São Paulo, com 14 casos confirmados, e outro em Recife, com quatro casos. Como o organismo representa uma ameaça à saúde pública, a Anvisa considera qualquer ocorrência […]
Suspeito é preso por tentativa de fraude em teste físico da Polícia Penal da Bahia

Um homem foi detido nesta terça-feira (6) após tentar se passar por um candidato durante a etapa de testes de aptidão física do concurso da Polícia Penal da Bahia, realizada na Vila Militar, em Salvador. De acordo com a Secretaria de Administração Penitenciária (Seap), o suspeito, que teve a identidade preservada, apresentou documentos falsos e […]
PF faz operação em Salvador contra tráfico internacional de drogas

Agentes da Polícia Federal cumpriram, nesta quarta-feira (7), 21 mandados de busca e apreensão em Salvador, Rio de Janeiro, Niterói, São Paulo e Campinas contra um grupo criminoso envolvido com o tráfico internacional de drogas. A operação foi coordenada pela PF do Rio de Janeiro, com apoio de mais de 100 policiais federais e integrantes […]

